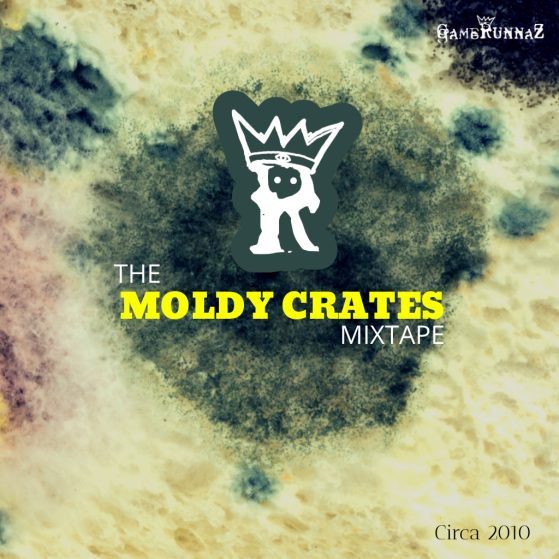

Release Radar: J.T. Pender Breaking ChainZ is streaming on all platforms! 🔥
J.T. Pender has dropped the Breaking ChainZ (Hype Cut) today! It’s a new cut and master of the extended version from The Breaking ChainZ Mixtape. Listen On All Platforms!
View this post on Instagram